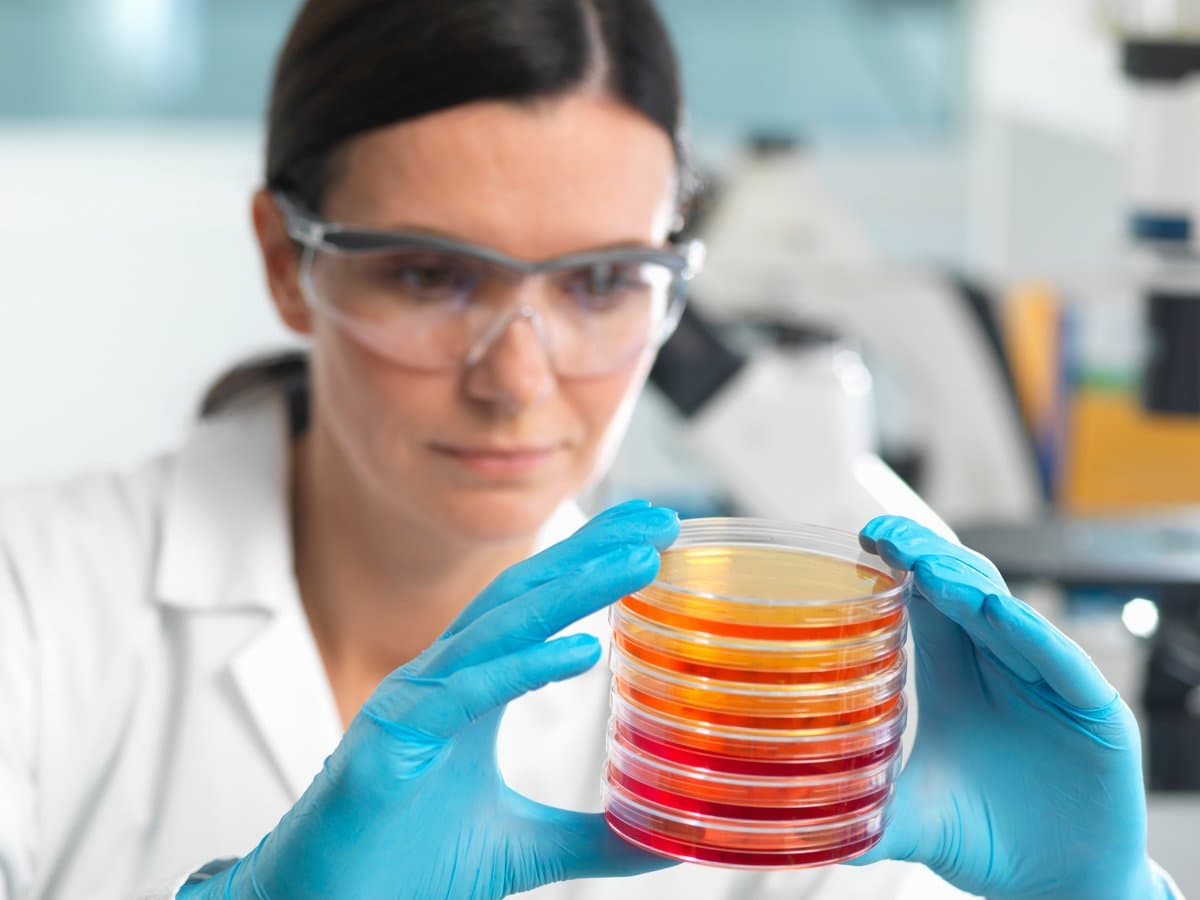

Funderar du över ditt framtida yrkesliv?
Är det viktigt för dig att ha ett betydelsefullt jobb där du kan göra skillnad för många människor? Vi är en stor arbetsgivare med många arbetsplatser och karriärmöjligheter. Hos oss får du möjlighet att växa och utvecklas i din yrkesroll.
Varje dag, dygnet runt arbetar vi med hälso- och sjukvård, kollektivtrafik, regional utveckling och kulturliv. Vi underlättar, berikar och förbättrar människors liv och hälsa.
Hos oss finns en bredd av yrken och möjligheter som få kan matcha. Tillsammans är vi 48 000 medarbetare. Och mitt i allt finns en plats för dig!
Anmäl dig till höstens universitets- och högskoleutbildningar på antagning.se(Extern länk)
Det här är Region Stockholm

Det här står vi för
Vi tror att varje individ kan göra skillnad för någon annan. Hos oss blir vardagen viktig.

Det här gör Region Stockholm
Vi ansvarar för hälso- och sjukvård, kollektivtrafik, regional utveckling samt bidrar till kulturlivet i Stockholms län. Varje dag. Dygnet runt.

Möt våra medarbetare
Bli inspirerad av våra medarbetare som berättar om sina jobb.

Dina förmåner
När du jobbar hos oss får du en rad förmåner som gör din vardag tryggare och mer balanserad.
Utvecklas hos oss
Hos oss har du stora möjligheter att växa och utvecklas.
- Uppdaterad: 1 juli 2025